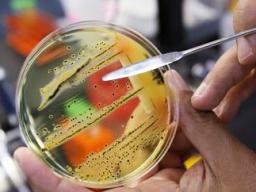

![At the fifth anniversary of the Jan. 6, 2021, attack on the Capitol, the official plaque honoring the police who defended democracy is nowhere to be found. About 100 members of Congress have mounted replicas outside their office doors now, at the U.S. Capitol in Washington. t“We should stop this silliness of trying to whitewash history — it’s not going to happen,” said Rep. Joe Morelle, D-N.Y., who helped lead the effort to display the replica plaques. “I was here that day so I’ll never forget,” he said. “I think that Americans will not forget what happened.” Instead of one plaque, he said, they’ve “now got 100.” [AP Photo] Replica of the official plaque honoring the police who defended democracy](/sites/default/files/styles/article_hero/public/field/image/honoring_jan_6_anniversary.jpeg?itok=KiuEUJ-t)
Associated Press
The “Jan. 6 plaque” was made to honor law enforcement. It’s nowhere to be found at the Capitol
WASHINGTON (AP) — Approaching the fifth anniversary of the Jan. 6, 2021, attack on the Capitol, the official plaque honoring the police who defended democracy that day is nowhere to... Read More
admin
January 6, 2026
7 min read



![Alanna Irving, who is originally from San Francisco and who moved to New Zealand six years ago, poses in Wellington, New Zealand. [photo: AP]](/sites/default/files/styles/article_horizontal/public/field/image/web1_5052668-c3dff23bd86a43a2a93c3125cfc85356.jpeg?itok=ttPADRqR)